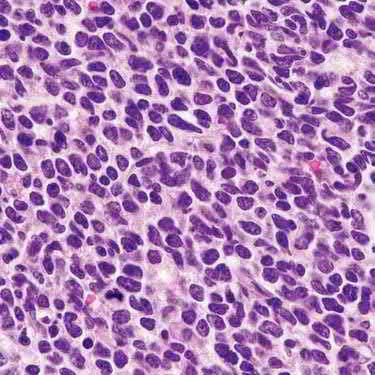

https://ebookmass.com/product/diagnostic-pathology-familialcancer-syndromes-2nd-edition-vania-nose-md-phd/
Instant digital products (PDF, ePub, MOBI) ready for you
Download now and discover formats that fit your needs...
Diagnostic Pathology: Familial Cancer Syndromes 2nd Edition Uk
https://ebookmass.com/product/diagnostic-pathology-familial-cancersyndromes-2nd-edition-uk/
ebookmass.com
Diagnostic Pathology: Endocrine 2nd Edition Vania Nosé
https://ebookmass.com/product/diagnostic-pathology-endocrine-2ndedition-vania-nose/
ebookmass.com
Diagnostic Pathology: Molecular Oncology 2nd Edition Mohammad A Vasef Md
https://ebookmass.com/product/diagnostic-pathology-molecularoncology-2nd-edition-mohammad-a-vasef-md/
ebookmass.com
Shifting Corporealities in Contemporary Performance: Danger, Im/mobility and Politics 1st ed. Edition Marina Gržini■
https://ebookmass.com/product/shifting-corporealities-in-contemporaryperformance-danger-im-mobility-and-politics-1st-ed-edition-marinagrzinic/ ebookmass.com
Official Google Cloud Certified Professional Data Engineer
Study Guide 1st Edition Dan Sullivan
https://ebookmass.com/product/official-google-cloud-certifiedprofessional-data-engineer-study-guide-1st-edition-dan-sullivan/
ebookmass.com
2022/2023 ASVAB For Dummies 11th Edition Angie Papple
Johnston
https://ebookmass.com/product/2022-2023-asvab-for-dummies-11thedition-angie-papple-johnston/
ebookmass.com
Oxford Handbook of Evolutionary Medicine 1st Edition
Martin Brüne
https://ebookmass.com/product/oxford-handbook-of-evolutionarymedicine-1st-edition-martin-brune/
ebookmass.com
Innovation in Nano-polysaccharides for Eco-sustainability: From Science to Industrial Applications Preeti Singh
https://ebookmass.com/product/innovation-in-nano-polysaccharides-foreco-sustainability-from-science-to-industrial-applications-preetisingh/
ebookmass.com
Dark Space: Advena Abductions Book Three Hollie Hartwright https://ebookmass.com/product/dark-space-advena-abductions-book-threehollie-hartwright/
ebookmass.com
The Philip B. Whyman
https://ebookmass.com/product/the-economics-of-brexit-revisited-1stedition-edition-philip-b-whyman/
ebookmass.com
Second Edition Vania
Nosé, MD, PhD Associate Chief of Pathology
Director of Anatomic and Molecular Pathology
Massachusetts General Hospital
Professor of Pathology
Harvard Medical School
Boston, Massachusetts
1600 John F. Kennedy Blvd.
Ste 1800 Philadelphia, PA 19103-2899
DIAGNOSTIC PATHOLOGY: FAMILIAL CANCER SYNDROMES, SECOND EDITION ISBN: 978-0-323-71204-0
Inkling: 978-0-323-71206-4
Copyright © 2020 by Elsevier. All rights reserved.
No part of this publication may be reproduced or transmitted in any form or by any means, electronic or mechanical, including photocopying, recording, or any information storage and retrieval system, without permission in writing from the publisher. Details on how to seek permission, further information about the Publisher’s permissions policies and our arrangements with organizations such as the Copyright Clearance Center and the Copyright Licensing Agency, can be found at our website: www.elsevier.com/permissions.
This book and the individual contributions contained in it are protected under copyright by the Publisher (other than as may be noted herein).
Notices Practitioners and researchers must always rely on their own experience and knowledge in evaluating and using any information, methods, compounds or experiments described herein. Because of rapid advances in the medical sciences, in particular, independent verification of diagnoses and drug dosages should be made. To the fullest extent of the law, no responsibility is assumed by Elsevier, authors, editors or contributors for any injury and/or damage to persons or property as a matter of products liability, negligence or otherwise, or from any use or operation of any methods, products, instructions, or ideas contained in the material herein.
Previous edition copyrighted 2013.
Library of Congress Control Number: 2019956687
Printed in Canada by Friesens, Altona, Manitoba, Canada
Dedication Developing a comprehensive book like this could only be accomplished with high levels of amazing teamwork. I would like to acknowledge and thank so many remarkable people for their support and contributions to this book. I will start with my parents, Dalva and Antonio Nosé, for their support, invaluable teaching and guidance, and for being my life examples. To my wonderful sons and best friends, Gustave, Erick, and Phillip, and their wives, Carla, Suzana, and Bianca, and to my grandsons, Nicolas, Leonardo, and Lucas Antonio, you all make my life so lovely and complete. To my brothers, Dalton and Walton, and their families for their love and continuous support. To the outstanding and dedicated contributing authors of this book for their hard work and contributions to this unique project. To the wonderful Elsevier team for their extraordinary work in making this book a reality. My final thanks are to all my family, friends, residents, fellows, colleagues, and everyone who shares our love and commitment to a better understanding of familial cancer diseases.
TABLEOFCONTENTS PartI:DiagnosesAssociatedWith SyndromesbyOrgan AcuteLymphoblasticLeukemiaandNon-Hodgkin
Nardi,MD
BloodandBoneMarrowTable
ValentinaNardi,MD
G.PeturNielsen,MDandYinRexHung,MD,PhD
G.PeturNielsen,MDandYinRexHung,MD,PhD
18 MalignantPeripheralNerveSheathTumor
G.PeturNielsen,MDandYinRexHung,MD,PhD
G.PeturNielsen,MDandYinRexHung,MD,PhD 28 Rhabdomyosarcoma
G.PeturNielsen,MDandYinRexHung,MD,PhD
32 Schwannoma
G.PeturNielsen,MDandYinRexHung,MD,PhD
36 BoneandSoftTissueTable
G.PeturNielsen,MDandYinRexHung,MD,PhD
SECTION3:BREAST 46 BreastCarcinoma
SusanC.Lester,MD,PhDandDavidG.Hicks,MD 54 BreastTable
DavidG.Hicks,MDandSusanC.Lester,MD,PhD
SECTION4:ENDOCRINE
ADRENALCORTEX
58 AdrenalCorticalAdenoma
VaniaNosé,MD,PhD
62 AdrenalCorticalCarcinoma
VaniaNosé,MD,PhDandJulieGuilmette,MD
70 AdrenalCorticalNeoplasmsinChildren
VaniaNosé,MD,PhD
78 PrimaryPigmentedNodularAdrenocorticalDisease
VaniaNosé,MD,PhD
84 AdrenalCortexTable
VaniaNosé,MD,PhD
ADRENALMEDULLAANDPARAGANGLIA
88 AdrenalMedullaryHyperplasia
VaniaNosé,MD,PhD
92 NeuroblasticTumorsofAdrenalGland
VaniaNosé,MD,PhD
104 PheochromocytomaandParaganglioma
VaniaNosé,MD,PhDandArthurS.Tischler,MD
114 AdrenalMedullaandParagangliaTable
VaniaNosé,MD,PhD
PANCREAS 118 PancreaticNeuroendocrineNeoplasms
VaniaNosé,MD,PhD
128 EndocrinePancreasTable
VaniaNosé,MD,PhD
PARATHYROID
130 ParathyroidAdenoma
VaniaNosé,MD,PhDandLoriA.Erickson,MD
136 ParathyroidCarcinoma
VaniaNosé,MD,PhDandLoriA.Erickson,MD
142 PrimaryParathyroidHyperplasia
LoriA.Erickson,MDandVaniaNosé,MD,PhD
152 ParathyroidTable
VaniaNosé,MD,PhD
PITUITARY
158 PituitaryAdenoma
M.BeatrizS.Lopes,MD,PhDandVaniaNosé,MD,PhD
164 PituitaryHyperplasia
M.BeatrizS.Lopes,MD,PhD
166 PituitaryTable
VaniaNosé,MD,PhD
THYROID,MEDULLARY
170 C-CellHyperplasia
VaniaNosé,MD,PhD
176 MedullaryThyroidCarcinoma
VaniaNosé,MD,PhD
186 Thyroid,MedullaryCarcinomaTable
VaniaNosé,MD,PhD
THYROID,NONMEDULLARY
188 FamilialThyroidCarcinoma
VaniaNosé,MD,PhD
200 FollicularThyroidCarcinoma
VaniaNosé,MD,PhD
TABLEOFCONTENTS 208 Thyroid,NonmedullaryCarcinomaTable
VaniaNosé,MD,PhD
SECTION5:GASTROINTESTINAL
HEPATOBILIARYANDPANCREAS
212 Hepatoblastoma
LarissaV.Furtado,MDandKarenS.Thompson,MD
218 HepatocellularCarcinoma
AmitabhSrivastava,MD
222 PancreaticAdenocarcinoma
AmitabhSrivastava,MDandVonSamedi,MD,PhD
226 BiliaryTract/Liver/PancreasTable
AmitabhSrivastava,MD
TUBULARGUT
228 ColonicAdenomas
Ying-HsiaChu,MDandVikramDeshpande,MD
234 EsophagealAdenocarcinoma
Ying-HsiaChu,MDandVikramDeshpande,MD
236 EsophagealSquamousCellCarcinoma
Ying-HsiaChu,MDandVikramDeshpande,MD
238 GastricAdenocarcinoma
Ying-HsiaChu,MDandVikramDeshpande,MD
244 GastrointestinalStromalTumor
Ying-HsiaChu,MDandVikramDeshpande,MD
252 HamartomatousPolyposisSyndromes
VaniaNosé,MD,PhDandAmitabhSrivastava,MD
262 SmallBowelAdenocarcinoma
Ying-HsiaChu,MDandVikramDeshpande,MD
268 Colon/RectumTable
JoelK.Greenson,MDandAmitabhSrivastava,MD
270 Esophagus/Stomach/SmallBowelTable
Ying-HsiaChu,MDandVikramDeshpande,MD
SECTION6:GENITOURINARY
BLADDER
274 BladderUrothelialCarcinoma
GladellP.Paner,MD,(BS)MT
282 BladderTable
GladellP.Paner,MD,(BS)MT
KIDNEY
286 Angiomyolipoma
GladellP.Paner,MD,(BS)MT
290 ClearCellRenalCellCarcinoma
GladellP.Paner,MD,(BS)MT
294 CysticNephroma
AlexanderJ.Gallan,MDandGladellP.Paner,MD,(BS) MT
296 HLRCCSyndrome-AssociatedRenalCellCarcinoma
AlexanderJ.Gallan,MDandGladellP.Paner,MD,(BS) MT
300 PapillaryRenalCellCarcinoma
GladellP.Paner,MD,(BS)MT
304 RenalOncocytoma,Chromophobe,andHybrid Tumors
GladellP.Paner,MD,(BS)MT
308 SuccinateDehydrogenase-DeficientRenalCell Carcinoma
AlexanderJ.Gallan,MDandGladellP.Paner,MD,(BS) MT
312 WilmsTumor
AlexanderJ.Gallan,MDandGladellP.Paner,MD,(BS) MT
320 KidneyTable
GladellP.Paner,MD,(BS)MT
PROSTATE 326 ProstateCarcinoma
GladellP.Paner,MD,(BS)MT
338 ProstateTable
GladellP.Paner,MD,(BS)MT
RENAL PELVIS
ANDURETER 344 RenalUrothelialCarcinoma
GladellP.Paner,MD,(BS)MT
348 UreterUrothelialCarcinoma
GladellP.Paner,MD,(BS)MT
350 RenalPelvisandUreterTable
GladellP.Paner,MD,(BS)MT
TESTICLE 352 GermCellTumor
GladellP.Paner,MD,(BS)MT
358 SertoliCellNeoplasms
GladellP.Paner,MD,(BS)MT
362 TesticleTable
GladellP.Paner,MD,(BS)MT
SECTION7:GYNECOLOGY
370 CervicalCarcinoma
FabiolaMedeiros,MD
372 FallopianTubeCarcinoma
FabiolaMedeiros,MD
374 OvarianTumors
FabiolaMedeiros,MD
380 EndometrialCarcinoma
FabiolaMedeiros,MD
384 GynecologicTumors
FabiolaMedeiros,MD
SECTION8:HEADANDNECK
390 EndolymphaticSacTumor
VaniaNosé,MD,PhD
394 HeadandNeckSquamousCellCarcinoma
VaniaNosé,MD,PhD
400 HeadandNeckTable
VaniaNosé,MD,PhD
404 SalivaryGlandsTable
VaniaNosé,MD,PhD
SECTION9:NERVOUSSYSTEM
412 CentralNervousSystem
FaustoJ.Rodríguez,MD
416 Eye
FaustoJ.Rodríguez,MD
TABLEOFCONTENTS 420 PeripheralNervousSystem
FaustoJ.Rodríguez,MD
SECTION10:PULMONARY
426 Adenocarcinoma,Lung
MariMino-Kenudson,MD
432 AdenocarcinomaWithLepidic(Bronchioloalveolar)
PredominantPattern
MariMino-Kenudson,MD
434 Lymphangioleiomyomatosis
MariMino-Kenudson,MD
438 NeuroendocrineTumor,Lung
MariMino-Kenudson,MDandYinRexHung,MD,PhD
442 PleuropulmonaryBlastoma
MariMino-Kenudson,MDandYinRexHung,MD,PhD
444 LungTable
MariMino-Kenudson,MD
SECTION11:SKIN
448 % $ 3 -InactivatedMelanocyticTumor
MaiP.Hoang,MD
450 BasalCellCarcinoma
MaiP.Hoang,MD
456 CutaneousMelanoma
MaiP.Hoang,MD
460 CutaneousSquamousCellCarcinoma
MaiP.Hoang,MD
466 SebaceousCarcinoma
MaiP.Hoang,MD
472 SkinTable
MaiP.Hoang,MD
PartII:OverviewofSyndromes SECTION1:INTRODUCTION
476 PathologyofFamilialTumorSyndromes
VaniaNosé,MD,PhD
484 ClinicalDiagnosisandManagementof Familial/HereditaryTumorSyndromes
VaniaNosé,MD,PhDandDanielC.Chung,MD
494 MolecularAspectsofFamilial/HereditaryTumor Syndromes
AlexanderCraigMackinnon,MD,PhD
SECTION2:SYNDROMES
502 AtaxiaTelangiectasia
FaustoJ.Rodríguez,MD
504 % $ 3 TumorPredispositionSyndrome
MaiP.Hoang,MD
506 BasalCellNevusSyndrome/GorlinSyndrome
MaiP.Hoang,MD
510 Beckwith-WiedemannSyndrome
VaniaNosé,MD,PhDandPatriciaNogueiradeSa,MD
518 Birt-Hogg-DubéSyndrome
MaiP.Hoang,MD
522 BloomSyndrome
ValentinaNardi,MD
524 Brooke-SpieglerSyndrome
MaiP.Hoang,MD
528 CarneyComplex
VaniaNosé,MD,PhD
536 ColonicCarcinomaSyndromes
JoelK.Greenson,MDandAmitabhSrivastava,MD
540 CostelloSyndrome
MaiP.Hoang,MD
542 Denys-DrashSyndrome
AlexanderJ.Gallan,MDandGladellP.Paner,MD,(BS)
MT
546 Diamond-BlackfanAnemia
ValentinaNardi,MD
548 DICER1Syndrome
VaniaNosé,MD,PhDandMichelleMenonMiyake,MD
556 DownSyndrome
ValentinaNardi,MD
560 DyskeratosisCongenita
MaiP.Hoang,MD
564 FamilialAcuteMyeloidLeukemiaand MyelodysplasticSyndrome
ValentinaNardi,MD
568 FamilialAdenomatousPolyposis
AlexandrosD.Polydorides,MD,PhDandVaniaNosé,MD, PhD
576 FamilialChordoma
G.PeturNielsen,MDandYinRexHung,MD,PhD
578 FamilialGastrointestinalStromalTumor
VaniaNosé,MD,PhDandDanielC.Chung,MD
584 FamilialInfantileMyofibromatosis
G.PeturNielsen,MDandYinRexHung,MD,PhD
586 FamilialIsolatedHyperparathyroidism
VaniaNosé,MD,PhD
590 FamilialNonmedullaryThyroidCarcinoma
VaniaNosé,MD,PhD
596 FamilialParagangliomaPheochromocytoma Syndrome
VaniaNosé,MD,PhDandArthurS.Tischler,MD
600 FamilialTesticularTumor
GladellP.Paner,MD,(BS)MT
602 FamilialUvealMelanoma
FaustoJ.Rodríguez,MD
604 FamilialWilmsTumor
AlexanderJ.Gallan,MDandGladellP.Paner,MD,(BS)
MT
606 FanconiAnemia
ValentinaNardi,MD
608 GlucagonCellHyperplasiaandNeoplasia
VaniaNosé,MD,PhD
610 Breast/OvarianCancerSyndrome:BRCA1
616
SusanC.Lester,MD,PhDandDavidG.Hicks,MD
Breast/OvarianCancerSyndrome:BRCA2
DavidG.Hicks,MDandSusanC.Lester,MD,PhD
620 HereditaryDiffuseGastricCancer
JoelK.Greenson,MDandDanielC.Chung,MD
TABLEOFCONTENTS 624 HereditaryLeiomyomatosisandRenalCell CarcinomaSyndrome
AlexanderJ.Gallan,MDandGladellP.Paner,MD,(BS) MT
628 HereditaryMixedPolyposisSyndrome
JoelK.Greenson,MD
630 MultipleOsteochondromas
G.PeturNielsen,MDandYinRexHung,MD,PhD
632 HereditaryNeuroblastoma
VaniaNosé,MD,PhD
636 HereditaryPancreaticCancerSyndrome
DanielC.Chung,MDandVaniaNosé,MD,PhD
640 HereditaryPapillaryRenalCellCarcinoma
GladellP.Paner,MD,(BS)MT
642 HereditaryParaganglioma/Pheochromocytoma Syndromes
VaniaNosé,MD,PhD
650 HereditaryProstateCancer
GladellP.Paner,MD,(BS)MT
652 HereditaryRenalEpithelialTumors,Others
GladellP.Paner,MD,(BS)MT
656 HereditaryRetinoblastoma
FaustoJ.Rodríguez,MD
658 HereditarySWI/SNFComplexDeficiencySyndromes
FaustoJ.Rodríguez,MD
660 Howel-EvansSyndrome/KeratosisPalmaresand PlantaresWithEsophagealCancer
MaiP.Hoang,MD
662 Hyperparathyroidism-JawTumorSyndrome
VaniaNosé,MD,PhD
668 JuvenilePolyposisSyndrome
DanielC.Chung,MD,GregoryY.Lauwers,MD,and AmitabhSrivastava,MD
674 Li-FraumeniSyndrome
DavidG.Hicks,MDandSusanC.Lester,MD,PhD
680 LynchSyndrome
JoelK.Greenson,MD,DanielC.Chung,MD,andVania Nosé,MD,PhD
686 McCune-AlbrightSyndrome
VaniaNosé,MD,PhD
692 Melanoma/PancreaticCarcinomaSyndrome
MaiP.Hoang,MD
696 MultipleEndocrineNeoplasiaType1(MEN1)
VaniaNosé,MD,PhD
704 MultipleEndocrineNeoplasiaType2(MEN2)
VaniaNosé,MD,PhDandMichelleMenonMiyake,MD
712 MultipleEndocrineNeoplasiaType4(MEN4)
VaniaNosé,MD,PhDandMichelleMenonMiyake,MD
718 MUTYH-AssociatedPolyposis
VaniaNosé,MD,PhD
720 NeurofibromatosisType1
VaniaNosé,MD,PhDandMichelleMenonMiyake,MD
728 NeurofibromatosisType2
FaustoJ.Rodríguez,MD
734 NijmegenBreakageSyndrome
ValentinaNardi,MD
736 PancreaticNeuroendocrineTumorSyndromes
VaniaNosé,MD,PhD
744 HamartomatousPolyps,Peutz-Jeghers
GregoryY.Lauwers,MDandAmitabhSrivastava,MD
750 PTEN-HamartomaTumorSyndromes
VaniaNosé,MD,PhD
758 RASopathies:NoonanSyndrome
ValentinaNardi,MD
762 RhabdoidPredispositionSyndrome
FaustoJ.Rodríguez,MD
766 Schwannomatosis
FaustoJ.Rodríguez,MD
770 Shwachman-DiamondSyndrome
ValentinaNardi,MD
772 SteatocystomaMultiplex
MaiP.Hoang,MD
774 TuberousSclerosisComplex
FaustoJ.Rodríguez,MD
780 TumorSyndromesPredisposingtoOsteosarcoma
G.PeturNielsen,MDandYinRexHung,MD,PhD
782 vonHippel-LindauSyndrome
VaniaNosé,MD,PhDandCarlaMartinsAlberti,MD
790 WernerSyndrome/Progeria
MaiP.Hoang,MD
794 WilmsTumor-AssociatedSyndromes
AlexanderJ.Gallan,MDandGladellP.Paner,MD,(BS)
MT
796 Wiskott-AldrichSyndrome
ValentinaNardi,MD
798 XerodermaPigmentosum
MaiP.Hoang,MD
PartIII:Reference SECTION1:MOLECULARFACTORS
804 MolecularFactorsIndex
VaniaNosé,MD,PhD
AcuteLymphoblasticLeukemiaandNon-HodgkinLymphoma CLINICALISSUES
•Acutelymphoblasticleukemia(ALL)
○Notexclusivelysporadicdisease
KEYFACTS ○RiskofdevelopingB-acutelymphoblasticleukemia(BALL)is2-4xincreasedamongsiblingsofaffectedchildren
•Numberofgeneticalterationsthatpredisposeindividuals todevelopmentofALLisgrowing
•ChildrenwithALLshouldhavethoroughhistoryand focusedphysicalexamorbereferredtoscreenfor potentialfamilialsyndrome
•Implicationsforpreimplantationgeneticdiagnosis, managementofpatientandrelatives,screeningofrelated stemcelldonors
DIAGNOSTICCHECKLIST
•FamilialB-ALLdueto
○Germline PAX5 mutations
○Germline ETV6 mutationsordeletions
○Germline SH2B3 mutations
(Left)Bonemarrowis100% cellular.Hematopoietic marrowisreplacedbyblasts withhighnuclear:cytoplasmic ratioconferringtheblue appearanceatlowpower. (Right)Lymphoidblastscan haveirregularnuclear contoursmimickingmyeloid blasts.Thechromatinis vesicular,anddistinctnucleoli canbeseen.
○GermlineIKZF1mutations
•ALLasmanifestationsofgeneticsyndromes
○Li-Fraumenisyndrome
○Downsyndrome
○Wiskott-Aldrichsyndrome
○Bloomsyndrome
○Ataxiatelangiectasiasyndrome
○Constitutionalmismatchrepairsyndrome
○Nijmegenbreakagesyndrome
○FamilialplateletdisorderduetoRUNX1mutations
○Fanconianemia
○Neurofibromatosistype1
○Noonansyndrome
•Geneticpredispositiontolymphoma
○Noknownsyndromespredisposingexclusivelyto lymphomas
○Syndromesleadingtoimmunodeficiencycanpredispose toNHL
(Left)High-powerviewshows bonemarrowinvolvedbyBALL.Thecellularityconsistsof sheetsofsmall-tomediumsizedblasts,withscant cytoplasm,slightlyindented, irregularnuclei,fine chromatin,andoccasional distinctnucleoli.(Right)Sheets ofimmaturecellswithopen chromatinanddistinctnucleoli consistentwithblastsare fillingthesinusesand replacingtheparenchyma.
B-ALL/LymphomainBoneMarrow
B-ALL/LymphomaMorphology
B-ALL/LymphomainBoneMarrowAspirate
B-ALL/LymphomainLymphNode
AcuteLymphoblasticLeukemiaandNon-HodgkinLymphoma TERMINOLOGY Abbreviations
•Acutelymphoblasticleukemia(ALL)
•Non-Hodgkinlymphoma(NHL)
ETIOLOGY/PATHOGENESIS
ALLasManifestationofGeneticSyndromes
•Li-Fraumeni(pediatrichypodiploidB-ALL)
•Downsyndrome(oftencharacterizedbysomaticCRLF2 rearrangements)
•Wiskott-Aldrichsyndrome
•Bloomsyndrome
•Ataxiatelangiectasia:T-ALL>B-ALL
•Constitutionalmismatchrepairsyndrome
•Nijmegenbreakagesyndrome:T-ALL>B-ALL
•Familialplateletdisorderwithpredispositiontomyeloid malignancyduetoRUNX1mutations(T-ALL)
•Fanconianemia
•NeurofibromatosistypeI
•Noonansyndrome
FamilialB-ALLSecondarytoGermlineMutationsin
GenesSomaticallyMutatedinALL
• PAX5
• ETV6
• SH2B3
• IKZF1
GeneticPredispositiontoLymphoma
•Currentlynoknownsyndromespredisposingexclusivelyto lymphomas(mostlyNHL)
•Syndromesleadingtoimmunodeficiencycanpredisposeto NHL
○Ataxiatelangiectasia(alsoatriskforHodgkinlymphoma)
○Bloomsyndrome
○Nijmegenbreakagesyndrome
○WiskottAldrichsyndrome
○Constitutionalmismatchrepairsyndrome
CLINICALISSUES
FamilialB-ALLDuetoGermline 3 $ ; ˘Mutations
•B-celltranscriptionfactorpairedboxproteinPAX5 is essentialfornormalB-celldevelopment
• PAX5 issomaticallydeleted,rearranged,orotherwise mutatedin~30%ofsporadicB-ALL
•Heterozygoushypomorphgermlinemutations(i.e., p.Gly183Ser)needsomaticlossofwild-typePAX5alleleto beleukemogenic
FamilialB-ALLDuetoGermline ( 7 9 ˇMutationsor Deletions
• ETV6isETSfamilytranscriptionalrepressoressentialfor bonemarrowhaematopoiesis
•Manygermline ETV6 variants havedominantnegative effectontranscriptionalrepressionmediatedbywild-type protein
•Heterozygousgermlinemutationsin ETV6 areassociated withthrombocytopeniaandpredispositiontoB-ALLwith hyperdiploidkaryotype
•25-30%ofpatientswithgermlineETV6mutationswill developB-ALL;inadditionsomemaydevelopsolidtumors &/ormyeloidmalignancies
FamilialB-ALLDuetoGermline 6 + % Mutations
•SH2Badaptorprotein3(SH2B3)gene(a.k.a. LNK) encodes negativeregulatorofcytokinesignalingandtyrosine kinases
• SH2B3playscriticalroleindevelopmentandfunctionof hematopoieticstemcellsandlymphoidprogenitors
•Biallelicgermlinelossoffunctionmutationsin SH2B3are associatedwithfamilialdevelopmentaldelay, autoimmunity,andB-ALL
•ALLwithsporadicorgermline SH2B3mutations,maybe sensitivetokinaseinhibitorsoragentsinhibitingactivated JAK-STATpathway
FamilialB-ALLDuetoGermline , . = ) Mutations
• IKZF1encodeszincfingertranscriptionfactorIKAROS, criticalregulatoroflymphoiddevelopment
•~0.9%ofpresumedsporadicpediatricB-ALLwillhave germlineIKZF1variants
•Germline IKZF1 variantstendtoclusteroutsideknown annotatedfunctionaldomains
•GermlineIKZF1alterationspredisposetoALL,withvariable penetrance,andpotentiallyreduceresponseto chemotherapyandkinaseinhibitors
•SomepatientswithgermlineIKZF1variantshaveB lymphopenia
MICROSCOPIC HistologicFeatures
•Histologicallyindistinguishablefrompediatricsporadic acutelymphoblasticleukemia/lymphomaandfrom sporadicHodgkinandnon-Hodgkinlymphomas
ANCILLARYTESTS GeneticTesting
•Targetedgenesequencingtodetectpointmutations, insertionsanddeletions
•Microarrays,multiplexligation-dependentprobe amplification-based(MLPA),ornext-generationsequencing assays todetectlarge-scalegenomic rearrangements &/or deletions
•Preferredtissueforgermlinegenetictestinginpatients withhematologicmalignancyareculturedskinfibroblasts
SELECTEDREFERENCES 1. PuiCHetal:Somaticandgermlinegenomicsinpaediatricacute lymphoblasticleukaemia.NatRevClinOncol.16(4):227-40,2019
2. RampersaudEetal:GermlinedeletionofETV6infamilialacute lymphoblasticleukemia.BloodAdv.3(7):1039-46,2019
3. ChurchmanMLetal:GermlinegeneticIKZF1variationandpredispositionto childhoodacutelymphoblasticleukemia.CancerCell.33(5):937-48.e8,2018
4. AuerFetal:InheritedsusceptibilitytopreB-ALLcausedbygermline transmissionofPAX5c.547G>A.Leukemia.28(5):1136-8,2014
5. Perez-GarciaAetal:GeneticlossofSH2B3inacutelymphoblasticleukemia. Blood.122(14):2425-32,2013
BloodandBoneMarrowTable GermlineMutationsandConditionsAssociatedWithIncreasedRiskofHematological Malignancies Disorder
Fanconianemia
Diamond-Blackfananemia
FANCA,FANCB*, FANCC,FANCD1 (BRCA2),FANCD2, FANCE,FANCF, FANCG,FANCI,FANCJ (BRIP1/BACH1), FANCL,FANCM, FANCN(PALB2), FANCO(RAD51C), FANCP(SLX4),FANCQ (ERCC4),FANCR (RAD51)**,FANCS (BRCA1),FANCT (UBE2T),FANCU (XRCC2),FANCV (MAD2L2/REV7)
RPL5,RPL11,RPL15, RPL23,RPL26,RPL27, RPL31,RPL35A, RPL36,RPS7,RPS10, RPS15,RPS17,RPS19, RPS24,RPS26,RPS27, RPS27A,RPS28, RPS29, GATA1 TSR2
Dyskeratosiscongenita DKC1
TERC
TERT
NOLA3/NOP10
NOLA2/NHP2
TINF2
WRAP53/TCAB1
CTC1
RTEL1
ACD/TPP1
PARN
NAF1
STN1
AR *X-linked **AD
MDS,AML,[ALL withFANCD1 (BRCA2)]
Squamouscell carcinomasofheadand neck,vulva,GItract;liver tumors;braintumors andWilmstumor [FANCD1(BRCA2)]
Shortstature,skin pigmentation,skeletaland thumbabnormalities, facialdysmorphisms, renal,gonadal,cardiac,GI, andCNSabnormalities
AD
MDS,AML Osteosarcoma,soft tissuesarcomas
Macrocyticanemia,short stature,thumb abnormalities,facial dysmorphisms,cleft lip/palate,PierreRobin syndrome,cardiacand genitourinary abnormalities
X-linked
X-linked
X-linked AD AD,AR AR AR AD AR AR AD,AR AD,AR AD,AR AD AD
MDS,AML,AA Squamouscell carcinomasofheadand neck,GItract
Naildystrophy,rash, leukoplakia,shortstature, pulmonaryfibrosis, vascularanomalies,early grayingofhair,hairloss; dental,CNS,GIandGU abnormalities
Shwachman-Diamondsyndrome SBDS AR MDS,AML - Shortstature,steatorrhea, metaphysealdysostosis
Severecongenitalneutropenia ELANE HAX1 AD AR MDS,AML - Neurological abnormalities
FamilialMDS/AMLwithmutated GATA2 GATA2 AD MDS,AML, CMML -
Warts,atypical mycobacteria, lymphedema,deafness, pulmonaryalveolar proteinosis,arteriovenous malformations
MIRAGEsyndrome SAMD9 AD MDS,AML - Shortstature,adrenal hypoplasia,infections; CNS,GI,GU,andskeletal abnormalities
Ataxia-pancytopeniasyndrome SAMD9L AD MDS,AML - Ataxia(variable)
Myeloidneoplasmwithmutated SRP72 AD MDS - Sensorineuralhearingloss
BloodandBoneMarrowTable GermlineMutationsandConditionsAssociatedWithIncreasedRiskofHematological Malignancies(Continued) Disorder Genes
SRP72
FamilialMDS/AMLwithmutated DDX41 DDX41 AD MDS,AML - -
Familialplateletdisorder withpropensityto myeloidmalignancy RUNX1 AD MDS,AML,ALL - Thrombocytopeniaand abnormalplatelet function
Thrombocytopenia2 ANKRD26 AD MDS,AML - Thrombocytopeniaand abnormalplatelet function
Thrombocytopenia5 ETV6 AD ALL,MDS,AML - Thrombocytopeniaand abnormalplatelet function
FamilialAMLwithCEBPA mutation CEBPA AD AML - -
Li-Fraumeni TP53 AD ALL,MDS,AML Breast,softtissue sarcomas,brain, adrenocortical carcinoma,lung,colon, pancreas,Wilms, prostate -
SusceptibilitytoALL3 PAX5 AD ALL - -
Constitutionalmismatch repairdeficiency syndrome
MLH1
PMS2
MSH2
MSH6 AR AR AR AR Lymphoma, ALL,AML CNS,GItract,other Caféaulaitspots,axillary freckling,Lischnodules, neurofibromas,intestinal adenomas
WiskottAldrich WAS X-linked Lymphoma, leukemia Thrombocytopenia, neutropenia,eczema, infections,autoimmune disorders
Nijmegenbreakagesyndrome NBN AR Lymphoma Gliomas, rhabdomyosarcoma, medulloblastoma
Bloomsyndrome BLM AR Lymphoma, MDS,ALL
Colon,skincancer, squamouscell carcinomasofheadand neck,Wilmstumor, and others,atearlyage
Ataxiatelangiectasia ATM AR Lymphoma, leukemia Solidtumors -
Noonansyndrome
Severemicrocephaly, abnormalfacies,other malformations
Facialrashwithbutterfly distribution,other dermatologic manifestations,chronic obstructivelungdisease, endocrineabnormalities
PTPN11,SOS1,RAF1, KRAS,NRAS,BRAF, MAP2K1 AD JMML Rhabdomyosarcoma, neuroblastoma Shortstature, macrocephaly,feeding difficulty,cardiacdefects, other
AD=autosomaldominant;AR=autosomalrecessive; A<L=acutemyeloidleukemia:ALL=acutelymphoblasticleukemia;JMML=juvenile myelomonocyticleukemia;MDS=myelodysplasicsyndrome.
GodleyLAetal:Geneticpredispositiontohematologicmalignancies:managementandsurveillance.Blood, 130(4):424-432),2017.